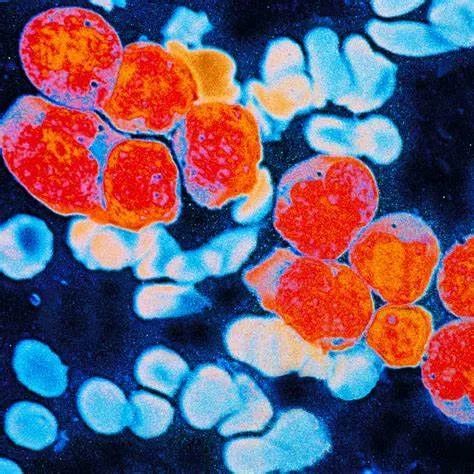

白血病是一种严重危害患者生命的疾病,而且治疗需要强大的经济实力做支撑。说到白血病,就想起少年时期,印象最深刻的韩剧《蓝色生死恋》,或者前两年感人泪下的电影《我不是药神》,抑或是经常会看到的某某大学生确诊白血病与病魔抗争事迹。大部分人都是从剧情或者新闻中了解到白血病:是一种非常严重,患了“要命”的绝症!
其实,白血病是一群癌症种类的统称,尽管早在公元前4世纪人们就知道这种血液病的存在,但直到1845年,在爱丁堡,约翰·休斯·贝内特(John Hughes Benett)正式诊断出该疾病。此后19世纪,几位欧洲医生注意到他们的很多患者患有异常高水平的白细胞,称为白血病。
白血病主要分为急性淋巴细胞白血病、急性髓细胞白血病、慢性淋巴细胞白血病、慢性髓细胞白血病4种类型,通常发病于骨髓,造成不正常白血球的大量增生,症状可能包含出血与瘀斑、疲倦以及感染风险增加。如果不经治疗,平均生存期仅3个月,经过治疗,大部分患者可以获得缓解,部分急性淋巴细胞白血病的治愈率可以达90%,但整体生存率还是比较低。

普通人与白血病人血液.formuladrugs
据世界卫生组织国际癌症研究机构(IARC)发布了2020年最新全球癌症负担数据,全球癌症死亡病例996万例,其中白血病死亡人数超30万,而我国白血病死亡人数达到6万。

全球癌症死亡人数.IARC

中国癌症死亡人数.IARC
《中国贫困白血病儿童生存状况调查报告》显示:白血病是一种需要长期治疗的疾病,一般需要2-3年时间,所需治疗费用10-30万,骨髓移植费用30-100万。白血病、部分淋巴瘤等肿瘤患儿,治疗周期以年为单位,要经历2-3年时间,期间需要多次住院治疗。因此,白血病的治疗需要强大的经济实力作支撑。
尽管近年来推出了几种针对该病的新药,但都未能显著改变患者的治疗效果或生存率。可喜的是,今年3月,伦敦国王学院白血病生物学教授兼主席Chi Wai Eric So博士发表在Science Translational Medicine的研究通过结合使用高度纯化的人类造血干细胞进行前瞻性疾病建模,并对原发患者样本中的白血病干细胞(LSCs)进行回顾,发现人类造血干细胞(HSCs)和普通骨髓祖细胞(CMPs)是由混合系白血病(MLL)基因融合驱动的人类急性髓系白血病(MLL-AML)的两种不同起源。并使用抗腹泻药物非达霉素减轻化疗耐药性。

人类HSC和CMP,而非LMPP或GMP是MLL融合介导的转化的细胞靶标。Functional reconstruction of human AML reveals stem cell origin and vulnerability of treatment-resistant MLL-rearranged leukemia. DOI: 10.1126/scitranslmed.abc4822
研究通过shRNA介导的敲除或使用小分子抑制剂菲达霉素(目前用于梭菌感染相关的腹泻)抑制ABCC3,有效地使HSC衍生的MLL-AML对标准化疗药物恢复敏感。该研究不仅从功能上确立了人LSCs对MLL-AML的两种独特起源及其在介导化疗耐药中的作用,而且通过重新利用一种已在临床上使用的耐受性良好的抗腹泻药物,为干细胞相关治疗耐药确定了一条潜在的治疗途径。
事实上,近期关于白血病药物治疗进展飞速。由澳大利亚莫那什大学团领导的23个国家148个地点的全球试验结果显示,急性髓系白血病(AML)患者的生存率提高了30%,显著提高了55岁以上老年患者的生存率,研究结果发表在NEJM上。

Oral Azacitidine Maintenance Therapy for Acute Myeloid Leukemia in First Remission. DOI: 10.1056/NEJMoa2004444
该研究进行了阿扎胞苷口服制剂(CC-486)3期,随机,双盲,安慰剂对照试验,472名患者随机分配接受CC-486(300 mg)或安慰剂治疗主要终点是总体生存率,次要终点包括无复发生存和与健康相关的生活质量。

治疗终点结果.DOI: 10.1056/NEJMoa2004444
结果显示,与安慰剂相比,CC-486随机分组后中位总生存期明显更长(P <0.001)。CC-486的中位无复发生存期也显着长于安慰剂组(P <0.001)。在根据基线特征定义的大多数亚组中,显示了CC-486在总体生存率和无复发生存率方面的优势。两组中最常见的不良事件是1级或2级胃肠道事件。常见的3级或4级不良事件是中性粒细胞减少(CC-486组为41%,安慰剂组为24%)和血小板减少症(分别为22%和21%)。在CC-486治疗期间,与健康相关的总体生活质量得以保留。
该研究可谓是白血病治疗史上里程碑式成果,众所周知,在强化化疗后,许多老年患者因不能接受干细胞移植,AML复发的风险很高。该药物的问世能显著延缓疾病的复发,从而延长生存期,且不影响生活质量。

inews.gtimg
对于白血病的治疗,医学科学界仍然处于不停探索的阶段。近年来,有不少学者陆续发现治疗白血病的新方案。而白血病包含复杂多种的亚型,其治疗仍然存在着探索空间。
近日,美国西奈山伊坎医学院(Icahn Mount Sinai)领导的一个研究小组建立了第一个细胞模型,发表在在Cell Stem Cell上的研究描绘了急性髓系白血病(AML)从早期到晚期的演变过程。通过使用基因编辑技术改变了使细胞变恶性的基因,确定了AML早期阶段的潜在治疗目标。

Sequential CRISPR gene editing in human iPSCs charts the clonal evolution of myeloid leukemia and identifies early disease targets.
DOI:10.1016 / j.stem.2021.01.011
白血病是通过顺序获取体细胞突变而产生的,这些突变产生了连续的克隆种群,病情进化模型可以帮助阐明这一过程并为疾病早期阶段的治疗干预提供信息,但其创建面临着巨大挑战。
因此,研究人员结合了诱导多能干细胞(iPSC)和CRISPR-Cas9技术来开发急性髓细胞白血病克隆进化模型。通过逐步引入三个驱动程序突变,生成了iPSC系,在造血分化时捕获了不同的恶性前阶段,包括克隆性造血(CH)和骨髓增生异常综合征(MDS),最终导致了可移植性白血病,并概括了转录和染色质可及性特征主要人类MDS和AML,重现一个正常细胞一步步转化为恶性细胞的过程。

动态变化图.DOI:10.1016 / j.stem.2021.01.011
通过绘制转录组和染色质景观的动态变化图,研究结果表征了驱动疾病阶段之间特定过渡的转录程序,发现炎症和先天性免疫途径构成了早期靶点,并证明这些途径的抑制剂,可能是AML和骨髓增生异常综合征的有希望的治疗方式。
nyulangone
综上,随着医学发展,白血病的药物治疗、靶向治疗、造血干细胞移植与细胞治疗等均取得了长足进步。然而对于患者来说,一旦患病对于本身、家庭、工作和经济来说都具有一定的负担。未来探索治疗新靶点, 开展新药临床实验, 优化干细胞移植,开拓可负担医疗途径将是新时代白血病的使命和方向。

如果觉得有用,
欢迎分享到朋友圈

个人中心
我是园区